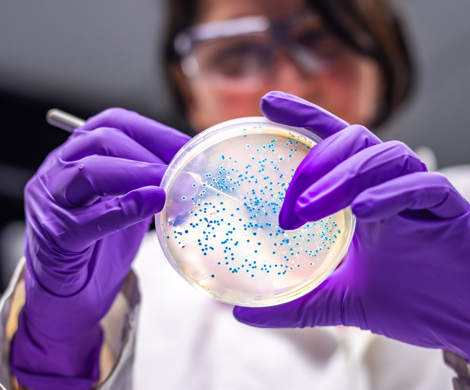

Kemisk arbejdsmiljø | Mikroorganismer
I nogle typer jobs er medarbejderne udsat for høje koncentrationer af mikroorganismer som bakterier, vira og svampesporer i arbejdsmiljøet, og det kan påvirke deres helbred negativt.

I nogle typer jobs er medarbejderne udsat for høje koncentrationer af mikroorganismer som bakterier, vira og svampesporer i arbejdsmiljøet, og det kan påvirke deres helbred negativt.
NFA forsker bl.a. i, hvordan man kan mindske udsættelsen for skadelige mikroorganismer i arbejdsmiljøer med problematisk eksponering.
I nogle typer jobs risikerer medarbejderne at indånde mikroorganismer, der kan gøre dem syge. Det kan være bakterier som fx MRSA, vira som den, der giver Roskildesyge, eller skimmelsvampe. NFA har derfor en vigtig opgave med at finde løsninger, der kan mindske medarbejdernes udsættelse for mikroorganismer på arbejdet.
NFA’s forskning fokuserer primært på de brancher og jobgrupper, som er mest udsatte for mikroorganismer i arbejdsmiljøet. Det er bl.a. ansatte i affalds- og genanvendelsesbranchen, på renseanlæg, biomasseanlæg og i landbruget.
Konkret arbejder NFA på at finde ud af, hvilke typer og niveauer af påvirkninger i arbejdsmiljøet, der kan være problematiske, hvis medarbejdere bliver udsat for dem. Vi arbejder også på at finde løsninger, der kan mindske den skadelige udsættelse for mikroorganismer. Det gør forskerne i tæt samarbejde med brancherne og de arbejdspladser, der bidrager til NFA’s forskning.
Mikroorganismer er levende organismer som virus, bakterier, mikroskopiske svampe og encellede alger og dyr, der er så små, at man ikke kan se dem med det blotte øje. De findes overalt - på overflader og i den omgivende luft.
Mange mikroorganismer er uskadelige for os eller findes i så små mængder, at de er uproblematiske. Men kroppen kommer på overarbejde, hvis man bliver udsat for skadelige mikroorganismer eller store mængder af mikroorganismer på jobbet. Sker det gennem en længere periode, kan det udløse kroniske luftvejssygdomme.
Medarbejdere risikerer også at indånde mikroorganismer, der kan gøre dem syge. Det kan være bakterier som fx MRSA, vira som den, der giver Roskildesyge, eller skimmelsvampe. NFA har derfor en vigtig opgave med at finde løsninger, der kan mindske medarbejderes udsættelse for mikroorganismer på arbejdet.
Overblik over forskningsprojekter (PURE portal)
Relevante projektsider
Overblik over rapporter og videnskabelige artikler (PURE portal)

Der findes pt. ingen webinarer eller podcasts for dette tema.
Der findes pt. ingen værktøjer for dette tema.

- Nogle mikroorganismer kan være skadelige, fx kan bestemte vira, bakterier eller svampe gøre medarbejderne syge, fordi de kan give infektioner. Andre mikroorganismer kan gøre ansatte syge, med fx. ODTS, hvis de indånder høje koncentrationer af dem. NFA undersøger bl.a. hvordan man bedst mindsker risikoen for at blive syg af mikroorganismer på arbejdet.